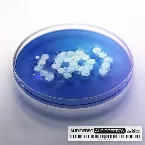
Pochette Audioception

Discographie de Audiofreq
8 maxis
28 singles
 Fragments1er Octobre 2025
Fragments1er Octobre 2025 Number One Thriller8 Septembre 2023
Number One Thriller8 Septembre 2023 Hardcore Maniac (DitzKickz Remix)17 Août 2023
Hardcore Maniac (DitzKickz Remix)17 Août 2023 Rave Is Religion21 Avril 2023
Rave Is Religion21 Avril 2023 Cyborg27 Mai 2022
Cyborg27 Mai 2022 Boss Mode24 Février 2022
Boss Mode24 Février 2022 Angel Eyez17 Décembre 2021
Angel Eyez17 Décembre 2021 Rub Ur Dick1er Octobre 2021
Rub Ur Dick1er Octobre 2021 Brainstomp (Partyraiser remix)30 Août 2021
Brainstomp (Partyraiser remix)30 Août 2021 Hardcore Maniac15 Juillet 2021
Hardcore Maniac15 Juillet 2021 Future Bass12 Mai 2021
Future Bass12 Mai 2021 The 9th Gate22 Octobre 2020
The 9th Gate22 Octobre 2020 Lose Control 5.017 Juillet 2020
Lose Control 5.017 Juillet 2020 The Ritual7 Juin 2019
The Ritual7 Juin 2019 Infinite28 Juin 2018
Infinite28 Juin 2018 Dragonblood (Defqon.1 Australia 2016 Anthem)9 Septembre 2016
Dragonblood (Defqon.1 Australia 2016 Anthem)9 Septembre 2016 Warcry15 Avril 2016
Warcry15 Avril 2016 Back To The Underground23 Juin 2015
Back To The Underground23 Juin 2015 Back to the Underground23 Juin 2015
Back to the Underground23 Juin 2015 Audiophetamine15 Juin 2015
Audiophetamine15 Juin 2015 Wake Up!12 Janvier 2015
Wake Up!12 Janvier 2015 Breakout7 Mars 2014
Breakout7 Mars 2014 Guardians of Time (Reverze 2014 Anthem)7 Février 2014
Guardians of Time (Reverze 2014 Anthem)7 Février 2014 Forgiven17 Septembre 2012
Forgiven17 Septembre 2012 Bring Me Down4 Mai 2012
Bring Me Down4 Mai 2012 We Are One!17 Avril 2012
We Are One!17 Avril 2012 Oncoming Storm22 Février 2012
Oncoming Storm22 Février 2012 GHYL (Gotta Have Your Love)Février 2012
GHYL (Gotta Have Your Love)Février 2012